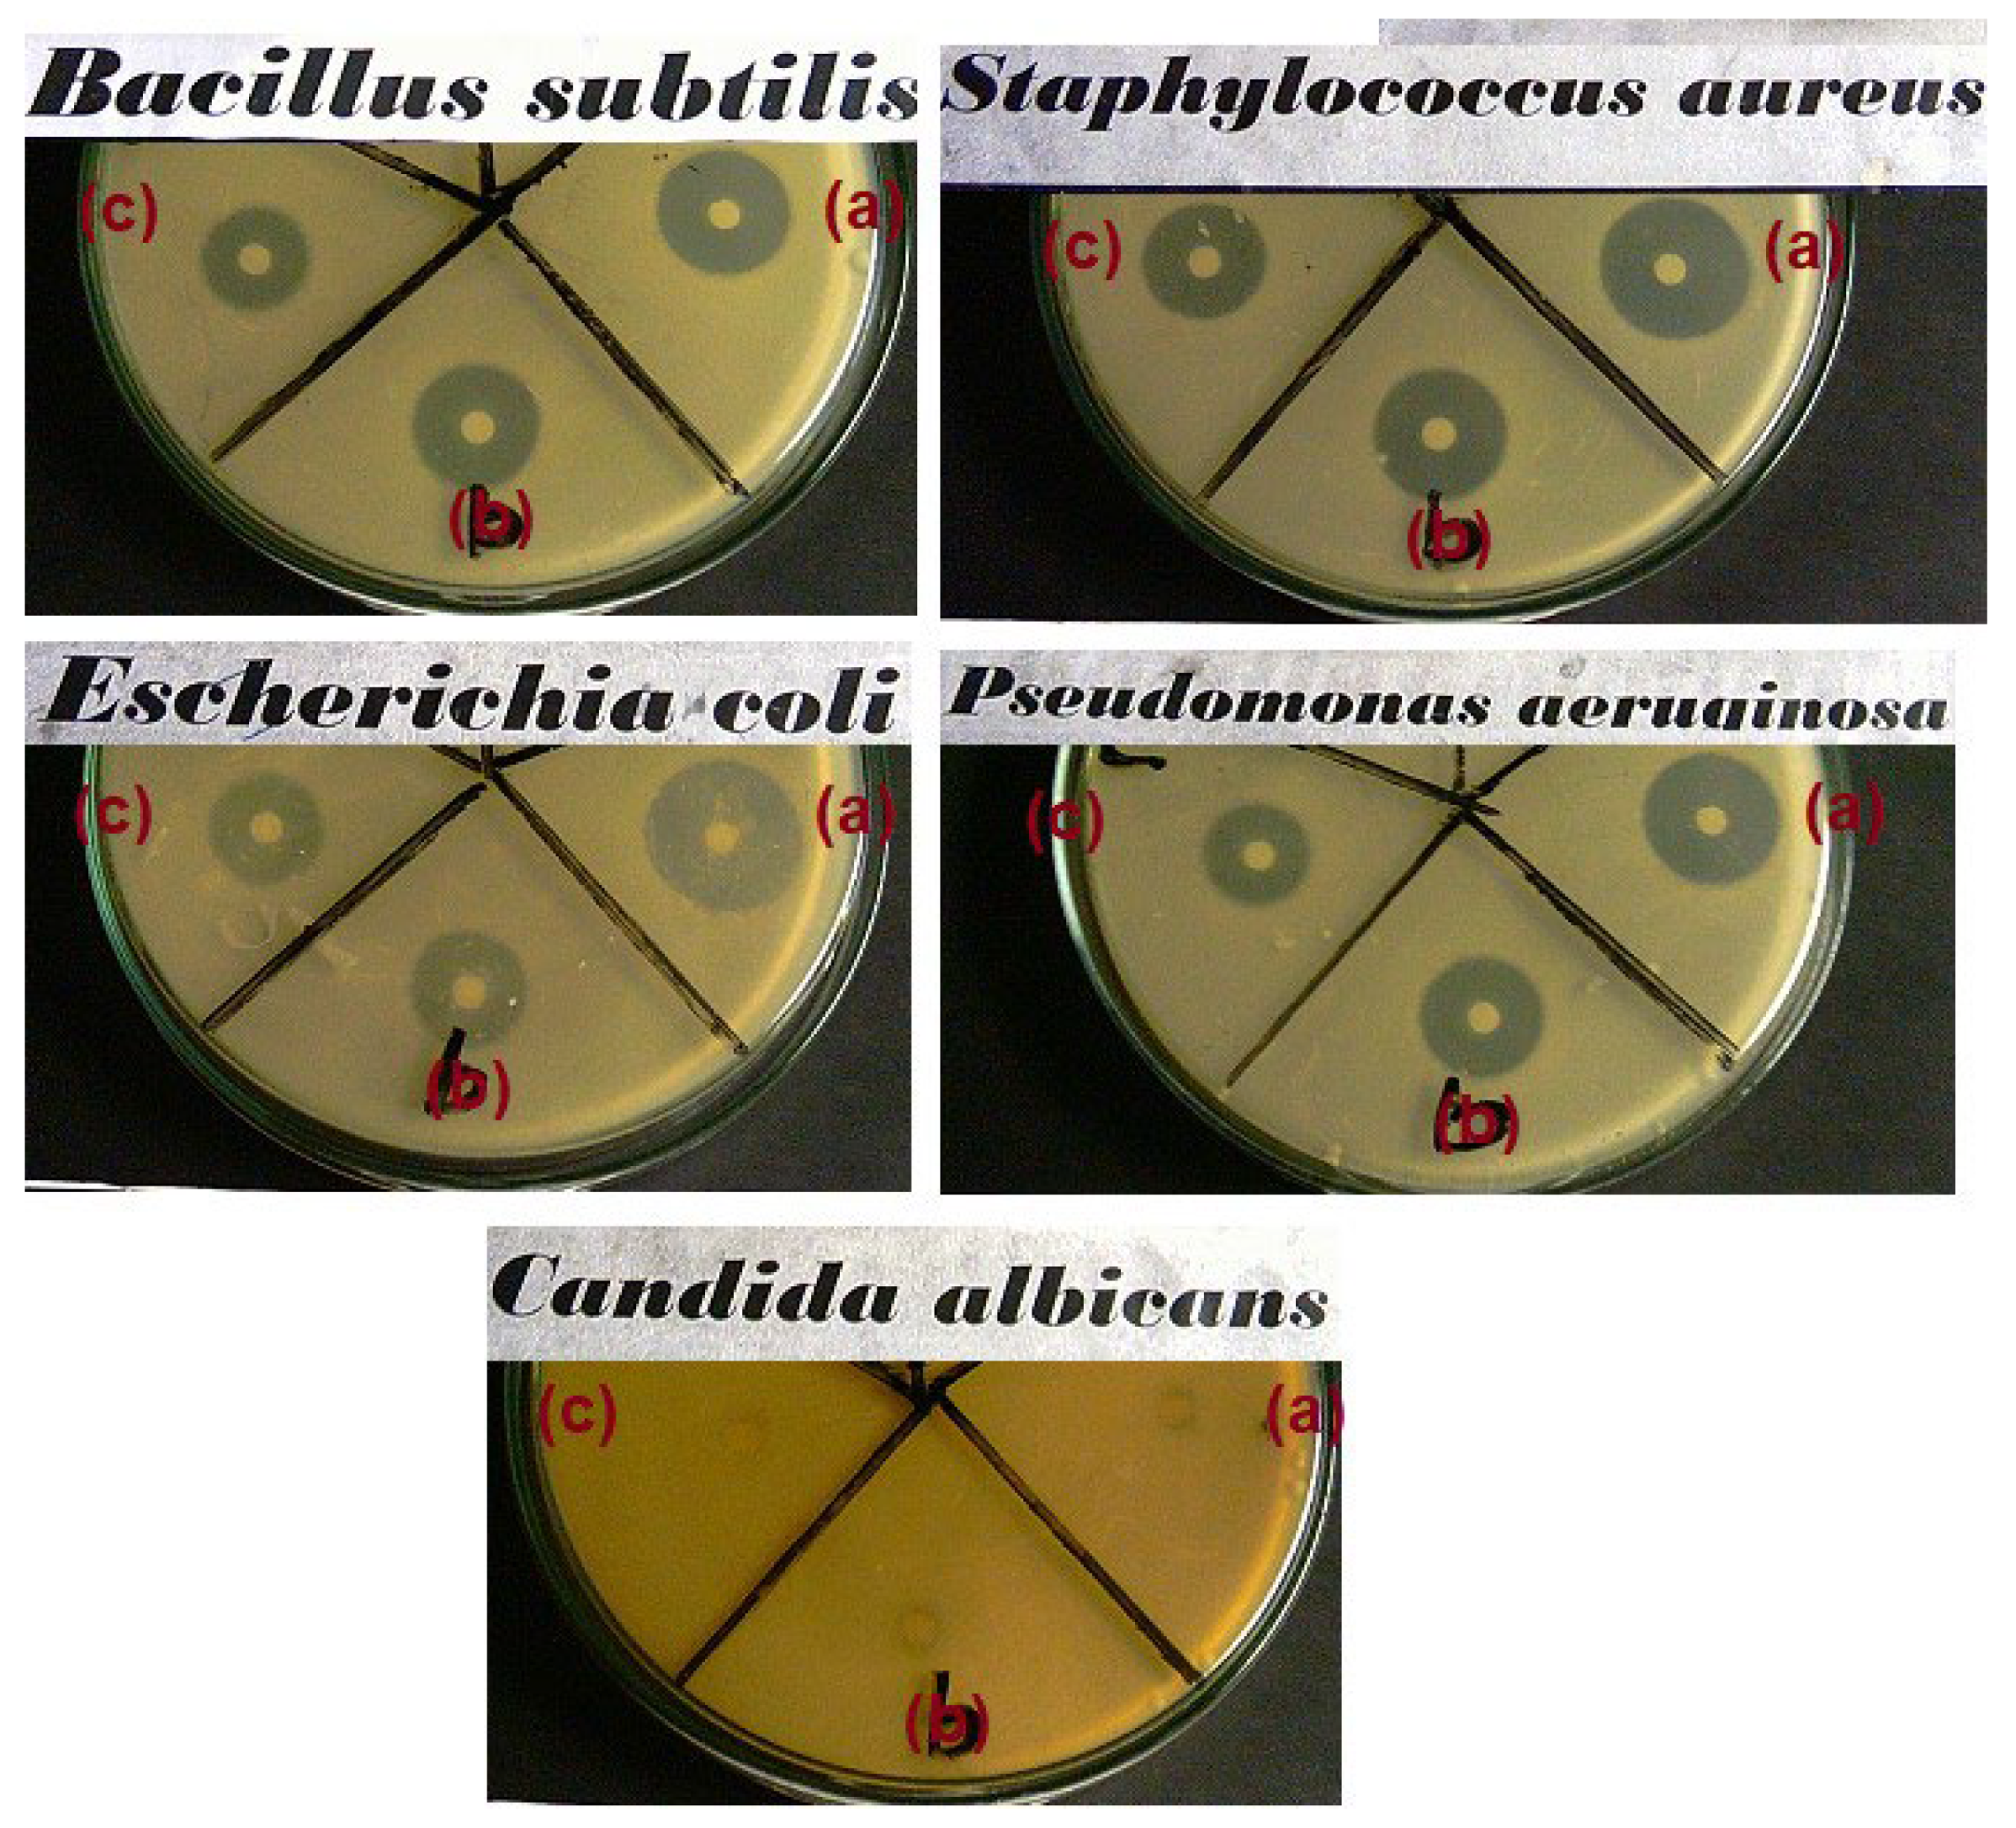
Materials 15 05789 g009 550

A Facile One-Pot Approach to the Fabrication of Nanocellulose–Titanium Dioxide Nanocomposites with Promising Photocatalytic and Antimicrobial Activity
Abstract
:1. Introduction
2. Materials and Methods
2.1. Materials and Reagents
2.2. Synthesis of NC–TiO2 Nanocomposite
2.3. Characterization of NC–TiO2 Nanocomposite
2.4. Photocatalytic Activity of NC–TiO2 Nanocomposite
2.5. Antimicrobial Activity of NC–TiO2 Nanocomposites
3. Results
3.1. Structural and Morphological Characterization of NC–TiO2 Nanocomposites
3.2. Photocatalytic and Antimicrobial Activity of NC–TiO2 Nanocomposites
4. Conclusions
Supplementary Materials
Author Contributions
Funding
Institutional Review Board Statement
Informed Consent Statement
Data Availability Statement
Acknowledgments
Conflicts of Interest
References
- Saveleva, M.S.; Eftekhari, K.; Abalymov, A.; Douglas, T.E.L.; Volodkin, D.; Parakhonskiy, B.V.; Skirtach, A.G. Hierarchy of Hybrid Materials—The Place of Inorganics-in-Organics in it, Their Composition and Applications. Front. Chem. 2019, 7, 179. [Google Scholar] [CrossRef] [PubMed] [Green Version]
- Singh, S.; Chen, H.; Shahrokhi, S.; Wang, L.P.; Lin, C.-H.; Hu, L.; Guan, X.; Tricoli, A.; Xu, Z.J.; Wu, T. Hybrid Organic−Inorganic Materials and Composites for Photoelectrochemical Water Splitting. ACS Energy Lett. 2020, 5, 1487–1497. [Google Scholar] [CrossRef]
- Mir, S.H.; Nagahara, L.A.; Thundat, T.; Mokarian-Tabari, P.; Furukawa, H.; Khosla, A. Organic-Inorganic Hybrid Functional Materials: An Integrated Platform for Applied Technologies. J. Electrochem. Soc. 2018, 165, B3137–B31556. [Google Scholar] [CrossRef]
- Adel, A.M.; Ibrahim, A.A.; El-Shafei, A.M.; Al-Shemy, M.T. Inclusion complex of clove oil with chitosan/β-cyclodextrin citrate/oxidized nanocellulose biocomposite for active food packaging. Food Packag. Shelf Life 2019, 20, 100307. [Google Scholar] [CrossRef]
- Adel, A.M.; Al-Shemy, M.T.; Diab, M.A.; El-Sakhawy, M.; Toro, R.G.; Montanari, R.; de Caro, T.; Caschera, D. Fabrication of packaging paper sheets decorated with alginate/oxidized nanocellulose-silver nanoparticles bio-nanocomposite. Int. J. Biol. Macromol. 2021, 181, 612–620. [Google Scholar] [CrossRef]
- Adel, A.M.; El-Shafei, A.M.; Ibrahim, A.A.; Al-Shemy, M.T. Chitosan/Nanocrystalline Cellulose Biocomposites Based on Date Palm (Phoenix dactylifera L.) Sheath Fibers. J. Renew. Mater. 2019, 7, 567–582. [Google Scholar] [CrossRef] [Green Version]
- Shopsowitz, K.E.; Stahl, A.; Hamad, W.Y.; MacLachlan, M.J. Hard templating of nanocrystalline titanium dioxide with chiral nematic ordering. Angew. Chem. 2012, 51, 6886–6890. [Google Scholar] [CrossRef]
- Zuo, H.-F.; Guo, Y.-R.; Li, S.-J.; Pan, Q.-J. Application of microcrystalline cellulose to fabricate ZnO with enhanced photocatalytic activity. J. Alloy. Compd. 2014, 617, 823–827. [Google Scholar] [CrossRef]
- Luo, Y.; Xu, J.; Huang, J. Hierarchical nanofibrous anatase-titania-cellulose composite and its photocatalytic property. Cryst. Eng. Comm. 2014, 16, 464–471. [Google Scholar] [CrossRef]
- Caschera, D.; Toro, R.G.; Federici, F.; Montanari, R.; de Caro, T.; Al-Shemy, M.T.; Adel, A.M. Green approach for the fabrication of silver-oxidized cellulose nanocomposite with antibacterial properties. Cellulose 2020, 27, 8059–8073. [Google Scholar] [CrossRef]
- Toro, R.G.; Diab, M.; de Caro, T.; Al-Shemy, M.; Adel, A.; Caschera, D. Study of the Effect of Titanium Dioxide Hydrosol on the Photocatalytic and Mechanical Properties of Paper Sheets. Materials 2020, 13, 1326. [Google Scholar] [CrossRef] [Green Version]
- Malviya, A.; Jaspal, D.; Sharma, P.; Dubey, A. Isothermal mathematical modeling for decolorizing water—A comparative approach. Sustain. Environ. Res. 2015, 25, 53–58. [Google Scholar]
- Nyangiwe, N.N.; Baatjie, B.; Greyling, C.; Khenfouch, M.; Maaza, M. The decolourisation of Methyl Orange and textile effluent under UV using commercial and synthesized nano-TiO2. J. Phys. Conf. Ser. 2018, 984, 012009. [Google Scholar] [CrossRef]
- Anaya-Esparza, L.M.; Ruvalcaba-Gómez, J.M.; Maytorena-Verdugo, C.I.; González-Silva, N.; Romero-Toledo, R.; Aguilera-Aguirre, S.; Pérez-Larios, A.; Montalvo-González, E. Chitosan-TiO2: A Versatile Hybrid Composite. Materials 2020, 13, 811. [Google Scholar] [CrossRef] [Green Version]
- Mohamed, M.A.; Salleh, W.N.W.; Jaafar, J.; Ismail, A.F.; Mutalib, M.A.; Sani, N.A.A.; Asri, S.; Ong, C.S. Physiochemical characteristic of regenerated cellulose/N-doped TiO2 nanocomposite membrane fabricated from recycled newspaper with photocatalytic activity under UV and visible light irradiation. Chem Engin. J. 2016, 284, 202–215. [Google Scholar] [CrossRef]
- Zhan, C.; Li, Y.; Sharma, P.R.; He, H.; Sharma, S.K.; Wang, R.; Hsiao, B.S. A study of TiO2 nanocrystal growth and environmental remediation capability of TiO2/CNC nanocomposites. RSC Adv. 2019, 9, 40565–40576. [Google Scholar] [CrossRef] [Green Version]
- Zhao, X.; Zhang, G.; Zhang, Z. TiO2-based catalysts for photocatalytic reduction of aqueous oxyanions: State-of-the-art and future prospects. Environ. Int. 2020, 136, 105453. [Google Scholar] [CrossRef]
- Li, G.; Park, S.; Rittmann, B.E. Developing an efficient TiO2-coated biofilm carrier for intimate coupling of photocatalysis and biodegradation. Water Res. 2012, 46, 6489–6496. [Google Scholar] [CrossRef]
- Toro, R.G.; Calandra, P.; Federici, F.; de Caro, T.; Mezzi, A.; Cortese, B.; Pellegrino, A.L.; Malandrino, G.; Caschera, D. Development of superhydrophobic, self-cleaning, and flame-resistant DLC/TiO2 melamine sponge for application in oil–water separation. J. Mater. Sci. 2020, 55, 2846–2859. [Google Scholar] [CrossRef]
- Liu, G.-Q.; Pan, X.-J.; Li, J.; Li, C.; Ji, C.-L. Facile preparation and characterization of anatase TiO2/nanocellulose composite for photocatalytic degradation of methyl orange. J. Saudi Chem. Soc. 2021, 25, 101383. [Google Scholar] [CrossRef]
- Xiao, H.; Li, J.; He, B. Anatase-Titania Templated by Nanofibrillated Celluloseand Photocatalytic Degradation for Methyl Orange. J. Inorg. Organomet Polym. 2017, 27, 1022–1027. [Google Scholar] [CrossRef]
- Adel, M.A.; El-Gendy, A.A.; Mohamed, D.A.; Abou-Zeid, R.E.; El-Zawawy, W.K.; Dufresne, A. Microfibrillated cellulose from agricultural residues. Part I: Papermaking application. Ind. Crops Prod. 2016, 93, 161–174. [Google Scholar] [CrossRef]
- Adel, A.M.; El-Shafei, A.; Ibrahim, A.; Al-Shemy, M.T. Extraction of oxidized nanocellulose from date palm (Phoenix dactylifera L.) sheath fibers: Influence of CI and CII polymorphs on the properties of chitosan/bionanocomposite films. Ind. Crops Prod. 2018, 124, 155–165. [Google Scholar] [CrossRef]
- Ibrahim, A.A.; Adel, A.M.; AbdEl–Wahab, Z.H.; Al–Shemy, M.T. Utilization of carboxymethyl cellulose based on bean hulls as chelating agent. Synthesis, characterization and biological activity. Carbohydr. Polym. 2011, 83, 94–115. [Google Scholar] [CrossRef]
- Najafidoust, A.; Allahyari, S.; Rahemi, N.; Tasbihi, M. Uniform coating of TiO2 nanoparticles using biotemplates for photocatalytic wastewater treatment. Ceram. Int. 2020, 46, 4707–4719. [Google Scholar] [CrossRef]
- Schenzel, K.; Fischer, S. NIR FT Raman Spectroscopy—A Rapid Analytical Tool for Detecting the Transformation of Cellulose Polymorphs. Cellulose 2001, 8, 49–57. [Google Scholar] [CrossRef]
- Schenzel, K.; Almlof, H.; Germgard, U. Quantitative analysis of the transformation process of cellulose I→cellulose II using NIR FT Raman spectroscopy and chemometric methods. Cellulose 2009, 16, 407–415. [Google Scholar] [CrossRef]
- Adel, A.M.; El-Wahab, Z.H.A.; Ibrahim, A.A.; Al-Shemy, M.T. Characterization of microcrystalline cellulose prepared from lignocellulosic materials. Part I: Acid catalyzed hydrolysis. Bioresour. Technol. 2010, 101, 124446–124455. [Google Scholar] [CrossRef]
- Shankar, S.; Rhim, J.W. Preparation of nanocellulose from micro-crystalline cellulose: The effect on the performance and properties of agar-based composite films. Carbohydr. Polym. 2016, 135, 18–26. [Google Scholar] [CrossRef]
- Li, S.; Hao, X.; Dai, X.; Tao, T. Rapid Photocatalytic Degradation of Pollutant from Water under UV and Sunlight via Cellulose Nanofiber Aerogel Wrapped by TiO2. J. Nanomater. 2018, 2018, 8752015. [Google Scholar] [CrossRef] [Green Version]
- Zong, E.; Wang, C.; Yang, J.; Zhu, H.; Jiang, S.; Liu, X.; Song, P. Preparation of TiO2/cellulose nanocomposites as antibacterial bio-adsorbents for effective phosphate removal from aqueous medium. Int. J. Biolog. Macromol. 2021, 182, 434–444. [Google Scholar] [CrossRef]
- De Almeida, J.C.; Correâ, M.T.; Koga, R.H.; Del Duque, D.M.S.; Lopes, O.F.; Gelson, T.S.; da Silva, T.; Ribeiro, C.; de Mendonça, V.R. Crystallization time in ZnO: The role of surface OH groups in its photoactivity. New J. Chem. 2020, 44, 18216–18224. [Google Scholar] [CrossRef]
- Cao, W.; Li, J.; Martí-Rossellò, T.; Zhang, X. Experimental study on the ignition characteristics of cellulose, hemicellulose, lignin and their mixtures. J. Energy Inst. 2019, 92, 1303–1312. [Google Scholar] [CrossRef] [Green Version]
- Ceylan, Ö.; Van Landuyt, L.; Rahier, H.; De Clerck, K. The effect of water immersion on the thermal degradation of cotton fibers. Cellulose 2013, 20, 1603–1612. [Google Scholar] [CrossRef]
- Coats, A.W.; Redfern, J.P. Kinetic Parameters from Thermogravimetric Data. Nature 1964, 201, 68–69. [Google Scholar] [CrossRef]
- El-Sabour, M.A.; Mohamed, A.L.; El-Meligy, M.G.; Al-Shemy, M.T. Characterization of recycled waste papers treated with starch/organophosphorus-silane biocomposite flame retardant. Nord. Pulp Pap. Res. J. 2021, 36, 108–124. [Google Scholar] [CrossRef]
- Li, Y.; Zhang, J.; Zhan, C.; Kong, F.; Li, W.; Yang, C.; Hsiao, B.S. Facile synthesis of TiO2/CNC nanocomposites for enhanced Cr(VI) photoreduction: Synergistic roles of cellulose nanocrystals. Carbohydr. Polym. 2020, 233, 115838. [Google Scholar] [CrossRef]
- Petrella, A.; Spasiano, D.; Cosma, P.; Rizzi, V.; Race, M.; Mascolo, M.C.; Ranieri, E. Methyl Orange Photo-Degradation by TiO2 in a Pilot Unit under Different Chemical, Physical, and Hydraulic Conditions. Processes 2021, 9, 205. [Google Scholar] [CrossRef]
- Rathod, M.; Moradeeya, P.G.; Haldar, S.; Basha, S. Nanocellulose/TiO2 composites: Preparation, characterization and application in the photocatalytic degradation of a potential endocrine disruptor, mefenamic acid, in aqueous media. Photochem. Photobiol. Sci. 2018, 17, 1301–1309. [Google Scholar] [CrossRef]
- Comparelli, R.; Fanizza, E.; Curri, M.L.; Cozzoli, P.D.; Mascolo, G.; Passino, R.; Agostiano, A. Photocatalytic degradation of azo dyes by organic-capped anatase TiO2 nanocrystals immobilized onto substrates. Appl. Catal. B Envir. 2005, 55, 81–91. [Google Scholar] [CrossRef]
- Matar, M.J.; Ostrosky-Zeichner, L.; Paetznick, V.L.; Rodriguez, J.R.; Chen, E.; Rex, J.H. Correlation between E-test, disk diffusion, and microdilution methods for antifungal susceptibility testing of fluconazole and voriconazole. Antimicrob. Agents Chemother. 2003, 47, 1647–1651. [Google Scholar] [CrossRef] [PubMed] [Green Version]
- Bhuiyan, M.S.H.; Miah, M.Y.; Pail, S.C.; Aka, T.D.; Saha, O.; Rahaman, M.M.; Sharif, M.J.I.; Habiba, O.; Ashaduzzaman, M. Green synthesis of iron oxide nanoparticle using Carica papaya leaf extract: Application for photocatalytic degradation of Remazol yellow RR dye and antibacterial activity. Helyon 2020, 6, e04603. [Google Scholar] [CrossRef] [PubMed]
- Slavin, Y.N.; Asnis, J.; Hafeli, U.O.; Bach, H. Metal nanoparticles; understanding the mechanism behind antibacterial activity. Int. J. Nanobiotech. 2017, 15, 65–85. [Google Scholar] [CrossRef] [PubMed]
- Maslana, K.; Zywicka, A.; Wenelska, K.; Mijowska, E. Boosting of Antibacterial Performance of Cellulose Based Paper Sheet via TiO2 nanoparticles. Int. J. Molec. Sci. 2021, 22, 1451. [Google Scholar] [CrossRef]

| Catalyst | Pollutant | Wavelength | Efficiency | Reference |
|---|---|---|---|---|
| TiO2/CNF | MO | 365 nm | 99% within 30 min | [20] |
| TiO2/NFC | MO | 365 nm | 95% within 60 min | [21] |
| CNF/TiO2 | MB | UV | 97% within 30 min | [30] |
| TiO2/RC | phenol | 365 nm | 96% within 360 min | [15] |
| TiO2/Agar | MB | UV | 62% within 105 min | [25] |
| NC/TiO2 | Mefenamic acid | UV | 89% within 150 min | [39] |
| NC/TiO2 | MO | 365 nm | 99% within 180 min | This work |
Publisher’s Note: MDPI stays neutral with regard to jurisdictional claims in published maps and institutional affiliations. |
© 2022 by the authors. Licensee MDPI, Basel, Switzerland. This article is an open access article distributed under the terms and conditions of the Creative Commons Attribution (CC BY) license (https://creativecommons.org/licenses/by/4.0/).
Share and Cite
Toro, R.G.; Adel, A.M.; de Caro, T.; Brunetti, B.; Al-Shemy, M.T.; Caschera, D. A Facile One-Pot Approach to the Fabrication of Nanocellulose–Titanium Dioxide Nanocomposites with Promising Photocatalytic and Antimicrobial Activity. Materials 2022, 15, 5789. https://doi.org/10.3390/ma15165789
Toro RG, Adel AM, de Caro T, Brunetti B, Al-Shemy MT, Caschera D. A Facile One-Pot Approach to the Fabrication of Nanocellulose–Titanium Dioxide Nanocomposites with Promising Photocatalytic and Antimicrobial Activity. Materials. 2022; 15(16):5789. https://doi.org/10.3390/ma15165789
Chicago/Turabian StyleToro, Roberta G., Abeer M. Adel, Tilde de Caro, Bruno Brunetti, Mona T. Al-Shemy, and Daniela Caschera. 2022. "A Facile One-Pot Approach to the Fabrication of Nanocellulose–Titanium Dioxide Nanocomposites with Promising Photocatalytic and Antimicrobial Activity" Materials 15, no. 16: 5789. https://doi.org/10.3390/ma15165789
APA StyleToro, R. G., Adel, A. M., de Caro, T., Brunetti, B., Al-Shemy, M. T., & Caschera, D. (2022). A Facile One-Pot Approach to the Fabrication of Nanocellulose–Titanium Dioxide Nanocomposites with Promising Photocatalytic and Antimicrobial Activity. Materials, 15(16), 5789. https://doi.org/10.3390/ma15165789

